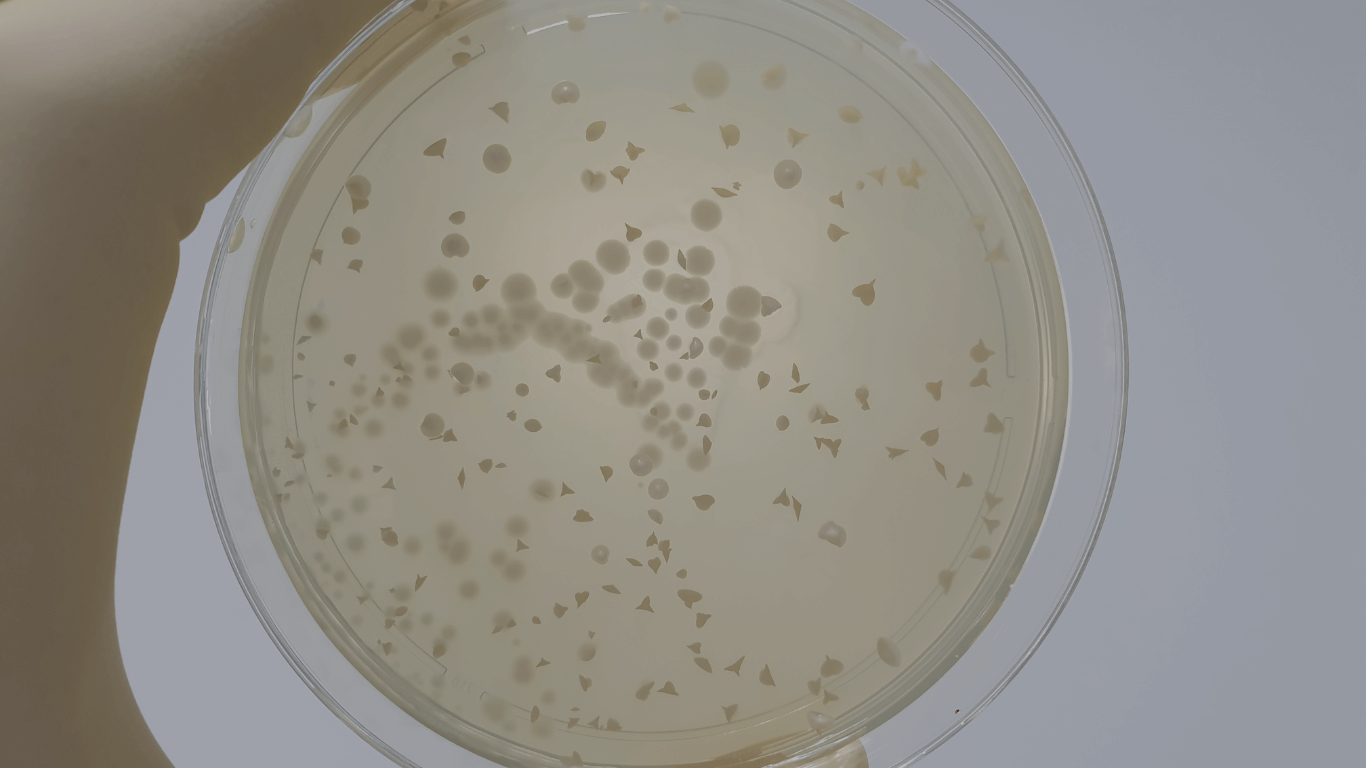
Laboratory mold testing results: A petri dish showing cultured spores and fungal growth after an indoor air quality assessment.

Who We Serve
Commercial Properties
Your trusted partner in maintaining healthy, compliant, and sustainable commercial environments.
Insurance Carriers
We understand the critical role you play in protecting your policyholders' assets and ensuring their well-being.
Contractors
Whether you’re building new or renovating, our specialized environmental services help protect your workforce, property owners, and occupants while ensuring a safe and compliant project environment.
Homeowners
Our experienced team delivers thorough environmental services designed to identify and resolve concerns in your home, giving you peace of mind.
Insurance Adjusters
We specialize in providing comprehensive environmental evaluations and remediation solutions for insurance claims. Through precise testing, rapid response times, and fast, reliable results, we help reduce claim severity and improve claims-to-loss ratios.
Property Managers
We focus on maintaining the well-being of your properties and ensuring tenant satisfaction while keeping your buildings compliant and reducing liability risks.
The Vert Way
Vert has got you covered for all of your property testing needs!
Our value proposition lies in our expertise and capabilities in providing comprehensive environmental testing services in Southern California and the Bay Area.
Combining extensive testing expertise, regulatory guidance, precise results, prompt turnaround, tailored solutions, and knowledgeable consulting, Vert Environmental is your trusted partner for property owners, businesses, and organizations seeking dependable and accurate environmental testing services.

From Inspection to Report, Clear Answers Fast.
Third-Party Environmental Testing You Can Trust.
Same-Day Testing | Certified Inspectors | Accredited Labs | Insured
Asbestos | Lead | Mold | Bacteria Industrial Hygiene Testing and Consulting

Proposal Work Testing
If your project requires an extensive scope of work, we will schedule a Job Walk to delve deeper into your project's unique testing requirements. Rest assured that within 24 hours of your request, we will provide a comprehensive proposal or quote. This is our commitment to delivering prompt, customized service tailored to your project's specific environmental testing needs.
Why Choose Vert Environmental as Your Certified Environmental Testing Partner in California
California-Certified Technicians
Our team consists of highly trained, California-certified technicians dedicated to delivering accurate and reliable environmental testing services.
12+ Years of California Experience
With over a decade of experience serving California clients, we understand local regulations and environmental challenges deeply.
Compliance Documentation, Done Right
We deliver detailed, regulatory-compliant documentation to support your reporting, insurance, and legal requirements.
Same-Day Service and Results
We offer same-day testing services with fast turnaround times, ensuring you receive results promptly to keep your project on track.
One Company, 12+ Tests
Vert Environmental provides a comprehensive range of over 12 different environmental tests, all managed under one trusted roof.
No Remediation Conflict of Interest
As an independent testing company, we maintain impartiality with no ties to remediation nor abatement services, ensuring unbiased results.
Your Trusted Partner for Environmental Testing in California
- San Diego County
- Imperial County
- Orange County
- Los Angeles County
- Riverside County
- San Bernardino County
- San Francisco County
- Alameda County
- Contra Costa County
- Santa Clara County
- San Mateo County
- And More...

Certifications
Our team of experts is certified by the following agencies and accredited programs to ensure that we provide superior services following all policies and procedures.